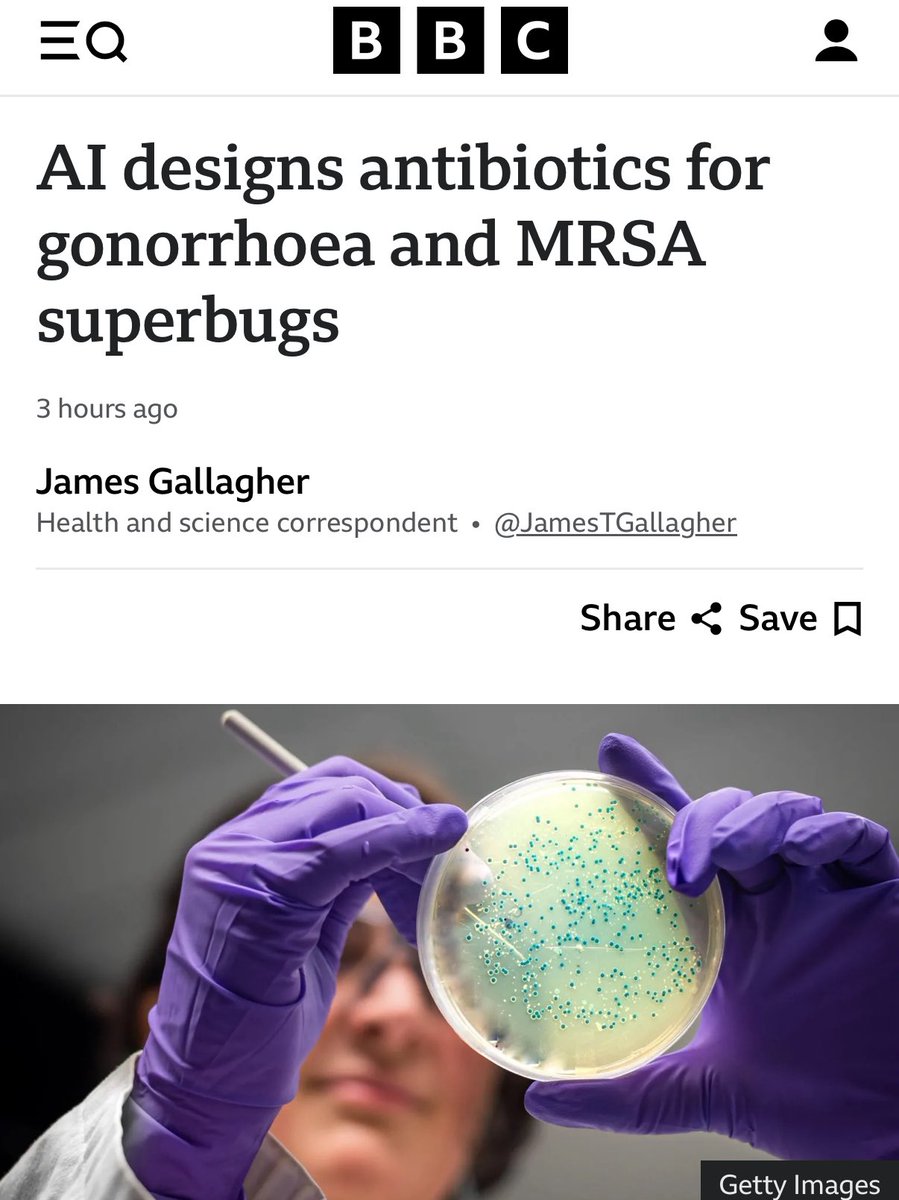
Edmund Loh Lab tweet media

Sabitlenmiş Tweet

Super happy and very proud to be part of this project. 😇🤓💊🦠Thanks @AmirAta8 @Aschtgen_MS @Margauxgab95392 @karolinskainst @MTC_KI in collaboration with Prof. James J. Collins at @MIT
”A generative deep learning approach to de novo antibiotic design”
cell.com/cell/abstract/…
English











































